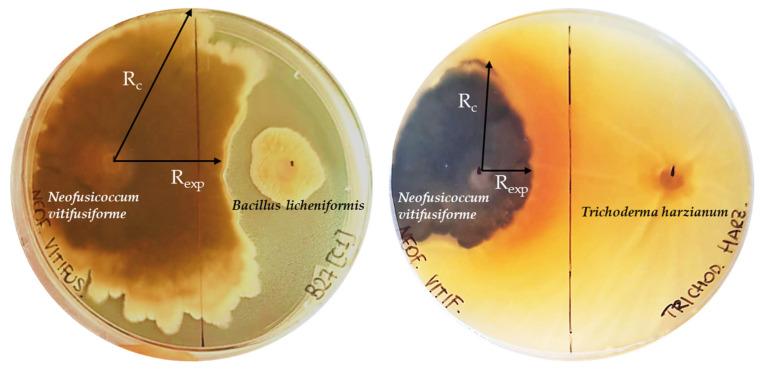
https://cdn.ncbi.nlm.nih.gov/pmc/blobs/9e6e/12298726/8a397ad8d379/microorganisms-13-01502-g005.jpg

西西里岛橄榄树的内生菌多样性:确定功能性微生物菌种保藏的最佳条件
Endophytic Diversity in Sicilian Olive Trees: Identifying Optimal Conditions for a Functional Microbial Collection.
作者信息
Crucitti Dalila, Barone Stefano, Navarro-Torre Salvadora, Quatrini Paola, Carimi Francesco, Caruso Tiziano, Pacifico Davide
机构信息
Institute of Biosciences and Bioresources (IBBR), National Research Council (CNR), Via Ugo La Malfa 153, 90146 Palermo, Italy.
Department of Agricultural, Food and Forest Sciences (SAAF), University of Study of Palermo, Viale delle Scienze, 90128 Palermo, Italy.
出版信息
Microorganisms. 2025 Jun 27;13(7):1502. doi: 10.3390/microorganisms13071502.
This study aims to identify the optimal conditions-host, plant material, seasonality, and agricultural practices-for isolating and developing a collection of culturable endophytic microorganisms to support sustainable L. cultivation. Samples were collected from three Sicilian olive cultivars ('Nocellara del Belice', 'Nocellara Etnea', and 'Nocellara Messinese') and six wild olive accessions across different phenological phases and under organic and conventional agronomic management. Endophytes were isolated from leaves and twigs using a culture-dependent approach, and their taxonomic diversity and plant-growth-promoting (PGP) traits were analyzed. A total of 133 endophytic isolates were identified, spanning bacterial (, , and ) and fungal ( and ) phyla. Wild olive trees contributed more than cultivated varieties to enriching the diversity and composition of culturable endophyte collection as well as twigs instead of leaves. Winter sampling allowed to implement the taxonomic genera of olive endophyte collection. Both farming systems favored an increase in the composition of microbial collection, though organic farming systems supported greater microbial richness. Functional analysis highlighted key PGP traits in a selection of bacterial isolates, including indole-3-acetic acid and siderophore production, nitrogen fixation, and antifungal activity. spp. dominated enzymatic activities, such as amylase, protease, and lipase production, as well as antifungal activity against the olive fungal pathogen . This research highlights the significant diversity and functional potential of Mediterranean olive endophytes. Our findings emphasize the role of native microbial communities as bio-inoculants, promoting plant growth, nutrient uptake, and disease resistance. These insights lay the groundwork for developing targeted olive-microbial consortia for biocontrol and stress tolerance applications.
本研究旨在确定用于分离和培养可培养内生微生物以支持可持续橄榄种植的最佳条件——宿主、植物材料、季节性和农业实践。从西西里岛的三个橄榄品种(“诺切拉·德尔·贝利切”、“诺切拉·埃特纳”和“诺切拉·梅西内塞”)以及六个野生橄榄种质中,在不同物候期且在有机和传统农艺管理下采集样本。采用依赖培养的方法从叶片和嫩枝中分离内生菌,并分析其分类多样性和促进植物生长(PGP)的特性。共鉴定出133株内生菌分离株,涵盖细菌(、和)和真菌(和)门。野生橄榄树对丰富可培养内生菌集合的多样性和组成的贡献超过栽培品种,嫩枝而非叶片也是如此。冬季采样有助于完善橄榄内生菌集合的分类属。两种种植系统都有利于增加微生物集合的组成,尽管有机种植系统支持更高的微生物丰富度。功能分析突出了一些细菌分离株的关键PGP特性,包括吲哚 - 3 - 乙酸和铁载体的产生、固氮和抗真菌活性。 spp. 在淀粉酶、蛋白酶和脂肪酶产生等酶活性以及对橄榄真菌病原体的抗真菌活性方面占主导地位。本研究突出了地中海橄榄内生菌的显著多样性和功能潜力。我们的研究结果强调了本地微生物群落作为生物接种剂促进植物生长、养分吸收和抗病性的作用。这些见解为开发用于生物防治和胁迫耐受性应用的靶向橄榄 - 微生物联合体奠定了基础。